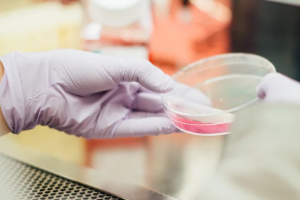

Oamenii de știință japonezi au creat cu succes carne de vită Kobe folosind imprimante 3D Bioprinter
#Postat de Antoniu Lovin on septembrie 16, 2021
Cu textura, forma și mirosul cărnii de vită originale Kobe, o echipă de oameni de știință japonezi a reușit să crească un produs cu celule stem reale. La prima vedere, nu există nicio diferență între carnea de vită originală Kobe și cea tipărită într-un laborator japonez. O echipă de oameni de știință de la Universitatea din Osaka a realizat o bioprintare 3D care reproduce fidel textura, forma și mirosul cărnii cele mai scumpe din lume. Deoarece au imitat aranjamentul mușchilor, grăsimii și vaselor de sânge, cercetătorii spun că au găsit o alternativă durabilă pentru cei care se bucură de aceste feluri de mâncare tradiționale.

Michichi Matsusaki, biochimist la Universitatea din Osaka, este sigur că a găsit o modalitate de a reproduce originalul , adică o ”rețetă” pentru a reproduce structura naturală a cărnii de vită Kobe. Dintr-un mediu controlat de laborator, acum va fi posibil să crești aceste produse pentru a „reproduce structuri complexe de carne, precum frumoasa Sashi [sau marmorare] de carne de vită Wagyu”, explică el pentru Smithsonian Magazine. Modelul de bioprintare este o alternativă mai ecologică la animale pentru aceste feluri de mâncare de elită. „Computerul generează straturi de material pentru a genera un proiect final tridimensional”, descriu autorii. Spre deosebire de alte tipăriri 3D, care utilizează materiale plastice sau metale, aceste produse din carne de laborator construiesc structuri complexe, cum ar fi vasele de sânge și țesutul muscular.
Aplicând celule stem reale de la vaci, pui și porci, obțineți o piesă artificială care are chiar venele Sashi sau Wagyu. Pentru a face acest lucru, oamenii de știință japonezi au folosit două tipuri de celule stem din rase specifice de vaci. Manipulându-le, era posibil să le cultivăm pentru a genera carne artificială. În acest fel, structurile complexe au fost imprimate pe produsul final, generând „o tăietură perfectă a cărnii de vită Kobe” „Folosind structura histologică a cărnii Wagyu ca model, am dezvoltat o metodă de imprimare 3D care poate produce structuri complexe la comandă, precum ca fibre musculare, grăsime și vase de sânge ”, a spus co-autorul Dong-Hee Kang într-o declarație.
Sursa: onepexel.com
Jurnal FM 